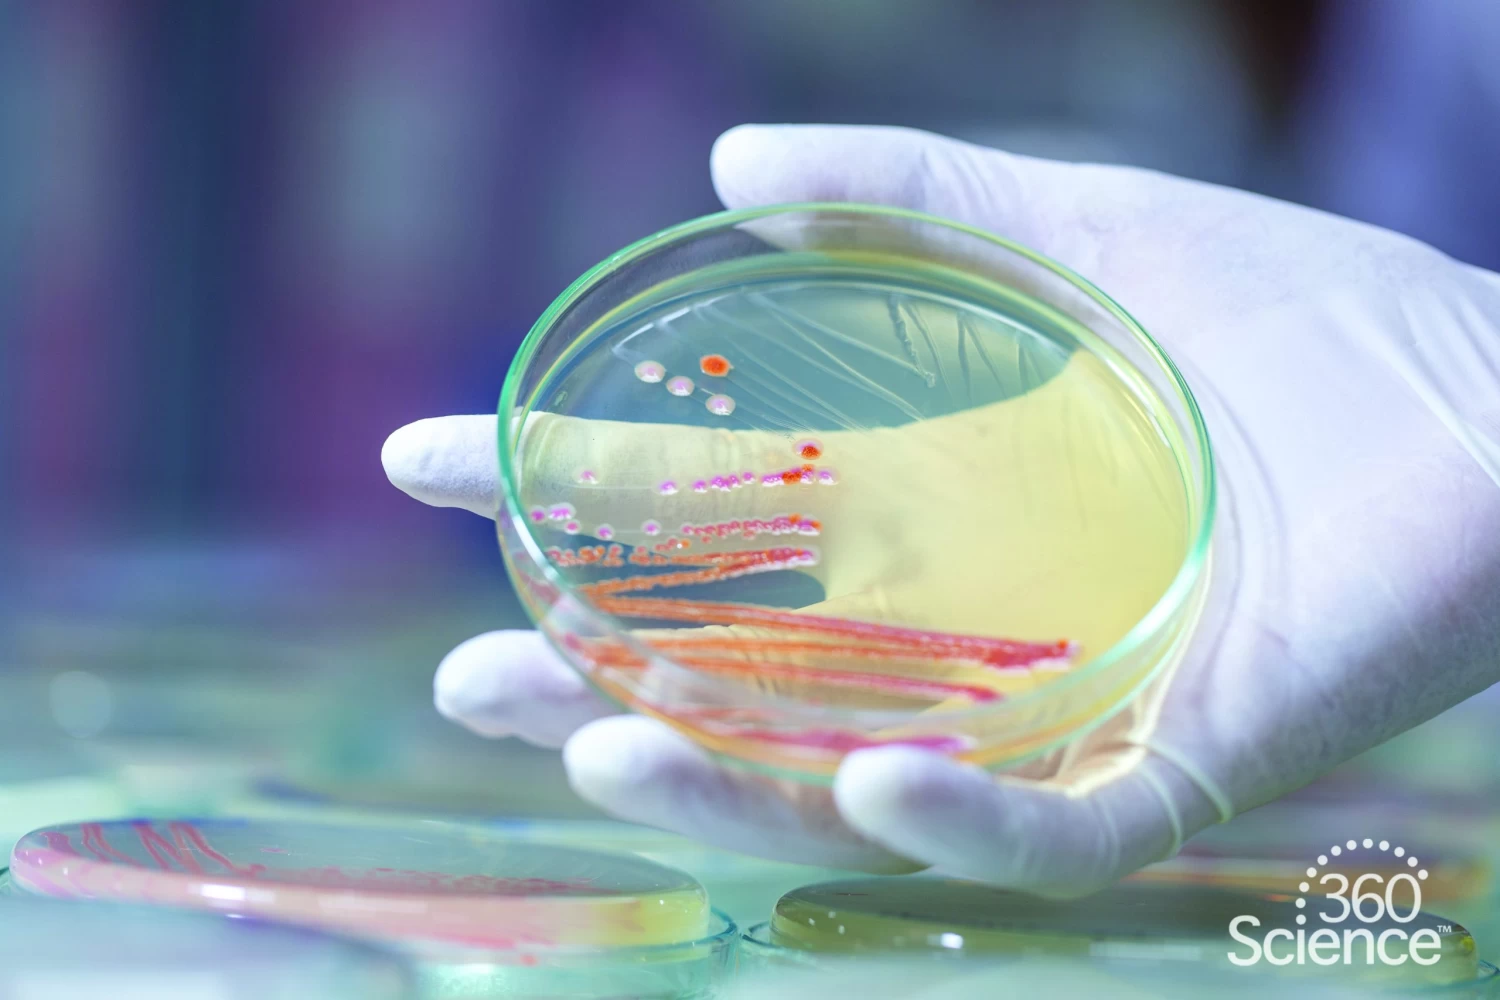
360Science™: Gene Expression In Bacteria 1 360Science™: Gene Expression In Bacteria

Product Details
360Science™: Gene Expression in Bacteria
Concepts: Microbiology, gene expression, transcription, translation, enzymes
Outcomes: Students will discover that the Serratia marcescens (available separately, Catalog No. LM1013) bacteria grown at room temperature or about 25 °C will result in smooth, dark red bacterial colonies. The bacteria at 5 °C are grown at a temperature in which the genes are expressed, and the enzymes responsible for the synthesis of prodigiosin are produced. The cultures grown at 37 °C will display white or pale pink colonies.
Associated Phenomena: Environmental Impacts on Genes
Our 1-year option provides access to all digital content for one year plus lab supplies for a single class of 30 students. Our 3-year option extends access to digital content to three years, with a 30% discount on refill supply kits years 2 and 3.
What is Flinn 360Science™?
We’re introducing a whole new way to teach experiential science! We’ve taken a hard look at science study from all perspectives and, thanks to the feedback of thousands of teachers nationwide, we’ve created a way to make it easier to provide personalized instruction while delivering the kind of lab experiences your students truly need.
Our new and comprehensive learning solutions are designed to bring science to life by giving you all the tools you need to incorporate more (and effective) hands-on learning in your classroom or lab. 360Science allows you to provide your students with the support they need to make real-world connections to key scientific principles and help make those abstract concepts concrete.
Every 360Science lab solves the most common challenges educators face in bringing more hands-on science to their students—from not having enough time to matching the right level of challenge for students’ abilities to providing appropriate background content, safety techniques, assessments and more.
Enable student-driven, blended learning through a unique combination of leveled lab instructions supporting prescriptive, guided- and open-inquiry lab exercises (see PDF resource for specific details) with robust digital content, such as videos and carefully curated Open Educational Resources (OER)—along with virtual reality and simulation exercises. From editable, digital instructions to assessments and alignment with Next Generation Science Standards (NGSS), we have everything you need to improve mastery, remove the intimidation factor and foster your students’ natural curiosity.

Reviews
There are no reviews yet.